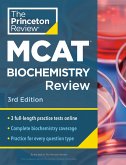

Gebundenes Buch
(A Graphic Novel)
7. Oktober 2025
Random House Children's Books


Broschiertes Buch
4. November 2025
Random House Children's Books

Broschiertes Buch
Complete Content Prep + Practice Tests
5th edition
4. November 2025
Random House Children's Books

Broschiertes Buch
Complete Behavioral Sciences Content Prep + Practice Tests
5th edition
4. November 2025
Random House Children's Books

Broschiertes Buch
4. November 2025
Random House Children's Books
Gebundenes Buch | ab 20,99 € | |
eBook, ePUB | 7,99 € |

Broschiertes Buch
Complete Content Prep + Practice Tests
5th edition
4. November 2025
Random House Children's Books

Gebundenes Buch
14. Oktober 2025
Random House Children's Books
Broschiertes Buch | 12,99 € | |
eBook, ePUB | 6,99 € |

Broschiertes Buch
4 Practice Tests + Digital Practice Online + Content Review
11th edition
5. August 2025
Random House Children's Books
eBook, ePUB | 9,95 € |

Gebundenes Buch
4. November 2025
Random House Children's Books

Buch mit Papp-Einband
A Shimmery, Shiny Christmas Book
23. September 2025
Random House Children's Books
Broschiertes Buch
Complete Content Prep + Practice Tests
3rd edition
4. November 2025
Random House Children's Books
Ähnlichkeitssuche: Fact®Finder von OMIKRON